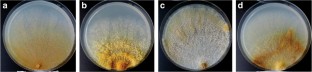

Abstract
Fomitiporia chilensis and Phylloporia boldo are described as new poroid species in the Hymenochaetaceae based on morphological, cultural, ecological, and phylogenetic analyses. Fomitiporia chilensis pertains to the Fomitiporia punctata species complex, being related to its Neotropical taxa. It is distinguished by pulvinate to effuse basidiomes that develop an indurated margin, by contextual tissue between the tube strata and basidiospores larger than 6.0 μm, and by growth on dead tissues of Peumus boldus and Cryptocarya alba. Its closest phylogenetic relatives are Fomitiporia neotropica and Fomitiporia impercepta, which differ by flatter basidiomes and by microscopical features. Phylloporia boldo grows and sporulates exclusively on living Peumus boldus. It is distinguished by a pileate basidiome with sulcate, indurated pileal surface, a dimitic hyphal system and by relatively large basidiospores 5.4–6.0 × 4.4–5.0 μm with dull chestnut walls. It was found to be phylogenetically related to Phylloporia dependens, described from China; both species being distantly related to other species in Phylloporia.

Similar content being viewed by others
References
Akaike H (1974) A new look at the statistical model identification. IEEE Trans Automatic Control 19:716–723
Amalfi M, Decock C (2013) Fomitiporia castilloi sp. nov. and multiple clades around F. apiahyna and F. texana in Meso- and South America evidenced by multiloci phylogenetic inferences. Mycologia 105:873–887. https://doi.org/10.3852/11-423
Amalfi M, Yombiyeni P, Decock C (2010) Fomitiporia in sub-Saharan Africa: morphology and multigene phylogenetic analysis support three new species from the Guineo-Congolian rainforest. Mycologia 102:1303–1317. https://doi.org/10.3852/09-083
Amalfi M, Raymundo T, Valenzuela R, Decock C (2012) Fomitiporia cupressicola sp. nov., a parasite on Cupressus arizonica, and additional unnamed clades in the southern USA and northern Mexico, determined by multilocus phylogenetic analyses. Mycologia 104:880–893. https://doi.org/10.3852/11-196
Amalfi M, Robledo G, Decock C (2014) Fomitiporia baccharidis comb. nov., a little known species from high elevation Andean forests and its affinities within the neotropical Fomitiporia lineages. Mycol Prog 13(995). https://doi.org/10.1007/s11557-014-0995-x
Cabrera AL (1971) Fitogeografía de la República Argentina. Bol Soc Argent Bot 14:1–42
Cabrera AL, Willink A (1973) Biogeografía de América Latina. ser. Biología, Monografía n° 13 Organización de Estados Americanos, Prog. Reg. Des. Cient. y Técn., Washington, 102 pp.
Cabrera AL, Willink A (1980) Biogeografía de América Latina. Secretaría General de la Organización de los Estados Americanos, Programa Regional de Desarrollo Científico y Tecnológico, Washington DC, 122 p
Campos Santana M, Amalfi M, Robledo G, Borges da Silveria RM, Decock C (2014) Fomitiporia neotropica, a new species from South America evidenced by multilocus phylogenetic analyses. Mycol Prog 13:601–615. https://doi.org/10.1007/s11557-013-0943-1
Dai YC (2010) Hymenochaetaceae (Basidiomycota) in China. Fungal Divers 45:131–343. https://doi.org/10.1007/s13225-010-0066-9
Dai YC, Cui BK, Yuan HS, Li BD (2007) Pathogenic wood-decaying fungi in China. For Path 37:105–120. https://doi.org/10.1111/j.1439-0329.2007.00485.x
Dai YC, Zhou LW, Cui BK, Chen YQ, Decock C (2010) Current advances in Phellinus sensu lato: medicinal species, functions, metabolites and mechanisms. Appl Microbiol Biotechnol 87:1587–1593. https://doi.org/10.1007/s00253-010-2711-3
Dai YC, Xue HJ, Vlasák J, Rajchenberg M, Wang B, Zhou LW (2014) Phylogeny and global diversity of Polyporus group Melanopus (Polyporales, Basidiomycota). Fungal Divers 64:133–144. https://doi.org/10.1007/s13225-013-0248-3
Decock C, Figueroa SH, Robledo G, Castillo G (2007) Fomitiporia punctata (Basidiomycota, Hymenochaetales) and its presumed taxonomic synonyms in America: taxonomy and phylogeny of some species from tropical/subtropical areas. Mycologia 99:733–752. https://doi.org/10.1080/15572536.2007.11832537
Donoso ZC (1993) Bosques templados de Chile y Argentina: variación, estructura y dinámica. Editorial Universitaria, Santiago, Chile. 484 pp.
Drechsler-Santos ER, Robledo G, Lima-Júnior NC, Malosso E, Reck MA, Gibertoni TB, de Queiroz Cavalcanti MA, Rajchenberg M (2016) Phellinotus gen. nov., a new neotropical genus in the Hymenochaetaceae (Basidiomycota, Hymenochaetales). Phytotaxa 261:218–239. https://doi.org/10.11646/phytotaxa.261.3.2
Fiasson JL, David A (1983) Approche taximétrique des hyménochétacées porées d’Europe (champignons, aphyllophorales). Can J Bot 61:442–451
Garrido N (1988) Agaricales s.l. und ihre Mykorrhizen in den Nothofagus-Wäldern Mittelchiles Bibl Mycol Band 120. J Cramer, Berlin-Stuttgart. ISBN 978-3-443-59021-5
Gilbertson RL, Ryvarden L (1986) North American Polypores vol. 1. Abortiporus-Lindtneria. Fungiflora, Oslo, p 433
Gilbertson RL, Ryvarden L (1987) North American Polypores vol. 2. Megasporoporia-Wrightoporia. Fungiflora, Oslo, pp 434–885
Gorjón SP, Hallenberg N (2012) A checklist of corticioid fungi from Chile. corticioids.webs.com/Checklists/Chile02(28.07.2012).pdf
Gorjón SP, Hallenberg N (2013) Some new species and a first checklist of corticioid fungi (Basidiomycota) from Chile. Mycol Prog 12:185–192. https://doi.org/10.1007/s11557-012-0824-z
Hall TA (1999) BioEdit: a user-friendly biological sequence alignment editor and analysis program for Windows 95/98/NT. Nucleic Acids Symp Ser 41:95–98
Hueck K (1978) Los bosques de Sudamérica. Eschborn, Sociedad Alemania de Cooperación Técnica (GTZ). 476 p
Katoh K, Standley DM (2013) MAFFT: multiple sequence alignment software 7: improvements in performance and usability. Mol Biol Evol 30:772–780. https://doi.org/10.1093/molbev/mst010
Larsen MJ, Cobb-Poulle LA (1990) Phellinus (Hymenochaetaceae) a survey of the world taxa. Syn Fung 3:1–206
Larsson KH, Parmasto E, Fischer M, Langer E, Nakasone KK, Redhead S (2006) Hymenochaetales: a molecular phylogeny for the hymenochaetoid clade. Mycologia 98:926–936. https://doi.org/10.1080/15572536.2006.11832622
Liu JK, Hyde KD, Gareth Jones EB, Ariyawansa HA, Bhat DJ, Boonmee S, Maharachchikumbura SSN, McKenzie EHC, Phookamsak R, Phukhamsakda C, Shenoy BD, Abdel-Wahab MA, Buyck B, Chen J, Chethana KWT, Singtripop C, Dai DQ, Dai YC, Daranagama DA, Dissanayake AJ, Doilom M, D’souza MJ, Fan XL, Goonasekara ID, Hirayama K, Hongsanan S, Jayasiri SC, Jayawardena RS, Karunarathna SC, Li WJ, Mapook A, Norphanphoun C, Pang KL, Perera RA, Peršoh D, Pinruan U, Senanayake IC, Somrithipol S, Suetrong S, Tanaka K, Thambugala KM, Tian Q, Tibpromma S, Udayanga D, Wijayawardene NN, Wanasinghe D, Wisitrassameewong K, Zeng XY, Abdel-Aziz FA, Adamčík S, Bahkali AH, Boonyuen N, Bulgakov T, Callac P, Chomnunti P, Greiner K, Hashimoto A, Hofstetter V, Kang JC, Lewis D, Li XH, Liu XZ, Liu ZY, Matsumura M, Mortimer PE, Rambold G, Randrianjohany E, Sato G, Sri-Indrasutdhi V, Tian CM, Verbeken A, Brackel Wv, Wang Y, Wen TC, Xu JC, Yan JY, Zhao RL, Camporesi E (2015) Fungal diversity notes 1-110 taxonomic and phylogenetic contributions to fungal species. Fungal Divers. https://doi.org/10.1007/s13225-015-0324-y
Matheny PB (2005) Improving phylogenetic inference of mushrooms with RPB1 and RPB2 nucleotide sequences (Inocybe; Agaricales). Molec Phylog Evol 35:1–20. https://doi.org/10.1016/j.ympev.2004.11.014
Matheny PB, Wang Z, Binder M, Curtis JM, Lim YW, Nilsson RH, Hughes KW, Hofstetter V, Ammirati JF, Schoch CL, Langer E (2007) Contributions of RPB2 and tef1 to the phylogeny of mushrooms and allies (Basidiomycota, Fungi). Molec Phylog Evol 43:430–451. https://doi.org/10.1016/j.ympev.2006.08.024
Miettinen O, Rajchenberg M (2012) Obba and Sebipora, new polypore genera related to Cinereomyces and Gelatoporia (Polyporales, Basidiomycota). Mycol Prog 11:131–147. https://doi.org/10.1007/s11557-010-0736-8
Minter DW, Peredo López H (2006) Fungi of Chile. www.cybertruffle.org.uk/chilfung (website, version 1.00)
Morera G, Robledo G, Ferreira-Lopes V, Urcelay C (2017) South American Fomitiporia (Hymenochaetaceae, Basidiomycota) ‘jump on’ exotic living trees revealed by multi-gene phylogenetic analysis. Phytotaxa 321:277–286. https://doi.org/10.11646/phytotaxa.321.3.5
Mujica RF, Oherens BE (1967) Addenda a la Flora Fungosa Chilena II. Bol Técn Est Exper Agron 27:1–81
Mujica RF, Vergara CC (1945) Flora Fungosa Chilena. Min Agric Chile, Santiago, 199 pp.
Mujica RF, Vergara CC, Oehrens BE (1980) Flora Fungosa Chilena 2nd Ed. Ciencias Agrícolas n° 5, 308 pp. Santiago de Chile, Facultad de Agronomía, Universidad de Chile
Nobles MK (1965) Identification of cultures of wood-inhabiting Hymenomycetes. Can J Bot 43:1097–1139
Pildain MB, Rajchenberg M (2013) The phylogenetic position of Postia s.l. (Polyporales, Basidiomycota) from Patagonia, Argentina. Mycologia 105:357–367. https://doi.org/10.3852/12-088
Pildain MB, Pérez G, Robledo G, Pappano DB, Rajchenberg M (2017) Arambarria the pathogen involved in grapevine diseases, canker-rot of Eucalyptus and native trees wood-rots in the Southern Hemisphere. For Pathol 47:e12397. https://doi.org/10.1111/efp.12397
Pildain MB, Reinoso Cendoya R, Ortiz-Santana B, Becerra J, Rajchenberg M (2018) A discussion on the genus Fomitiporella (Hymenochaetaceae, Hymenochaetales) and first record of F. americana from southern South America. MycoKeys 38:77–91. https://doi.org/10.3897/mycokeys.38.27310
Posada D (2008) jModelTest: phylogenetic model averaging. Mol Biol Evol 25:1253–1256. https://doi.org/10.1093/molbev/msn083
Rajchenberg M (2006) Polypores (Basidiomycetes) from the Patagonian Andes Forests of Argentina Bibl Mycol Band 201, J. Cramer Verlag, Stuttgart. ISBN 978-3-443-59103-8. ISSN 0067-8066, 300 pp.
Rajchenberg M, Pildain MB (2012) Molecular studies reveal a speciation process within Ryvardenia cretacea (Polyporales, Basidiomycota). Kurtziana 37:7–13
Rajchenberg M, Robledo GL (2013) Pathogenic polypores in Argentina. For Pathol 43:171–184. https://doi.org/10.1111/efp.12032
Rajchenberg M, Gorjón SP, Pildain MB (2011) The phylogenetic disposition of Antrodia sl from Patagonia, Argentina. Australian Syst Bot 24:111–120. https://doi.org/10.1071/SB11003
Rajchenberg M, Pildain MB, Bianchinotti MV, Barroetaveña C (2015) The phylogenetic position of poroid Hymenochaetaceae (Hymenochaetales, Basidiomycota) from Patagonia, Argentina. Mycologia 107:754–767. https://doi.org/10.3852/14-170
Raymundo T, Decock C, Valenzuela R, Amalfi M, Cifuentes J, Pacheco-Mota L (2012) Nuevos registros del género Fomitiporia (Hymenochaetales, Basidiomycota) en México. Rev Mex Biodiv 83:313–328
Rehner SA, Buckley E (2005) A Beauveria phylogeny inferred from nuclear ITS and EF1-a sequences: evidence for cryptic diversification and links to Cordyceps teleomorphs. Mycologia 97:84–98. https://doi.org/10.1080/15572536.2006.11832842
Ronquist F, Teslenko M, van der Mark P, Ayres L, Darling A, Höhna S, Larget B, Liu L, Suchard MA, Huelsenbeck JP (2012) MrBayes 3.2: efficient Bayesian phylogenetic inference and model choice across a large model space. Syst Biol 61:539–542
Sandoval P, Rajchenberg M (2011) Fomitopsis minutispora, a new record of Polyporales for the Chilean mycobiota. Gayana Bot 68:329–332
Sandoval-Leiva P (2014) Inonotus crustosus (Basidiomycota, Polyporales), first record for the Chilean mycobiota. Gayana Bot 71:273–275
Singer R (1969) Mycoflora Australis. Beih Nova Hedw 29:1–405
Stalpers JA (1978) Identification of wood-inhabiting fungi in pure culture. Stud Mycol 16:1–248
Stamatakis A (2014) RAxML version 8: a tool for phylogenetic analysis and post-analysis of large phylogenies. Bioinformatics 30:1312–1313. https://doi.org/10.1093/bioinformatics/btu033
Tamura K, Stecher G, Peterson D, Filipski A, Kumar S (2013) MEGA6: molecular evolutionary genetics analysis version 6.0. Mol Biol Evol 30:2725–2729. https://doi.org/10.1093/molbev/mst197
Thiers B (2018) http://sweetgum.nybg.org/science/ih/ (accessed on 23 November 2018)
Valenzuela FE (1993) Estudio sistemático, corológico y ecológico de los Agaricales sensu lato de los bosques autóctonos de la región de los lagos en Chile. Tesis doctoral, Universidad de Alcalá de Henares. Alcalá de Henares, 374 p
Vilgalys R, Hester M (1990) Rapid genetic identification and mapping of enzymatically amplified ribosomal DNA from several Cryptococcus species. J Bacteriol 172:4238–4246. https://doi.org/10.1128/jb.172.8.4238-4246.1990
Wu SH, Dai YC, Hattori T, Yu TW, Wang DM, Parmasto E, Chang HY, Shih S-Y (2012) Species clarification for the medicinally valuable ‘sanghuang’ mushroom. Bot Stud 53:135–149
Zhou LW (2015) Four new species of Phylloporia (Hymenochaetales, Basidiomycota) from tropical China with a key to Phylloporia species worldwide. Mycologia 107:1184–1192. https://doi.org/10.3852/14-254
Zhou LW (2016) Phylloporia minutipora and P. radiata spp. nov. (Hymenochaetales, Basidiomycota) from China and a key to worldwide species of Phylloporia. Mycol Prog 15(57). https://doi.org/10.1007/s11557-016-1200-1
Zhou LW, Dai YC (2012) Phylogeny and taxonomy of Phylloporia (Hymenochaetales): new species and a worldwide key to the genus. Mycologia 104:211–222. https://doi.org/10.3852/11-093
Acknowledgments
This research was funded through MinCyT CH 13/06 (Argentina)—CONICYT (Chile) Bilateral Cooperation Program, PICT-MinCyT 2015/1933 (to MR), PICT-MinCyT 2015/1723 (to MBP), and FONDECYT 1151028.
Author information
Authors and Affiliations
Corresponding author
Additional information
Section Editor: Yu-Cheng Dai
Publisher’s note
Springer Nature remains neutral with regard to jurisdictional claims in published maps and institutional affiliations.
Rights and permissions
About this article
Cite this article
Rajchenberg, M., Pildain, M.B., Madriaga, D.C. et al. New Poroid Hymenochaetaceae (Basidiomycota, Hymenochaetales) from Chile. Mycol Progress 18, 865–877 (2019). https://doi.org/10.1007/s11557-019-01495-1
Received:
Revised:
Accepted:
Published:
Issue Date:
DOI: https://doi.org/10.1007/s11557-019-01495-1




